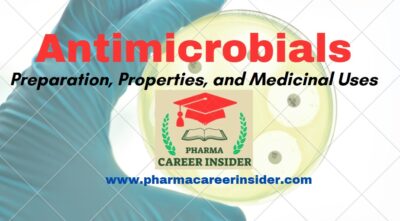
Antimicrobials Mechanism Classification And Uses

Antimicrobials Introduction Mechanism Classification
Antimicrobials Mechanism Classification And Uses Most of the classification systems include two primary categories, the first categorizing based on chemical structure and the second categorizing based on the mechanism of action. depending on. Classification of antimicrobials: antimicrobials are classified based on the type of organisms they target, their chemical structure, and their mechanism of action:.

Antimicrobials Mechanism Classification And Uses Learn about antimicrobials, their mechanisms, classification, and medical uses. discover their role in infection control, antimicrobial resistance, and best practices for responsible use. Discover the classification of antibiotics, their types, mechanisms of action, and medical uses. Cephalosporins overview bactericidal mechanism disrupts the synthesis of the peptidoglycan layer of bacterial cell walls does so through competitive inhibition on pcb (penicllin binding proteins). Concepts and terminologies how the use of antimicrobials is different? pk pd optimization concepts ‘syndrome – organism – antibiotic’ classification of agents based on mechanism of action.

Antimicrobials Mechanism Classification And Uses Cephalosporins overview bactericidal mechanism disrupts the synthesis of the peptidoglycan layer of bacterial cell walls does so through competitive inhibition on pcb (penicllin binding proteins). Concepts and terminologies how the use of antimicrobials is different? pk pd optimization concepts ‘syndrome – organism – antibiotic’ classification of agents based on mechanism of action. Recent molecular biological approaches have greatly helped to understand the mechanism of action in this paper by emphasizing the classification of antibiotics and molecular senses and reiterates optimal use of antibiotics. It does this by binding to the d ala d ala terminals of n acetylmuramic acid (nam) and n acetylglucosamine (nag) peptide subunits localized at the outer surface of the cell membrane. In this context, this article comprehensively explores the mechanism of action of various antibiotic classes and emphasizes the promising compounds currently in late clinical development. Common mechanisms of action of antimicrobials basic sites of antibiotic activity adapted from murray, rosenthal, pfaller. medical microbiology, 5th edition, elsevier mosby 2005.

Classification And Mechanism Of Action Of Antimicrobials By Dr Prince C Recent molecular biological approaches have greatly helped to understand the mechanism of action in this paper by emphasizing the classification of antibiotics and molecular senses and reiterates optimal use of antibiotics. It does this by binding to the d ala d ala terminals of n acetylmuramic acid (nam) and n acetylglucosamine (nag) peptide subunits localized at the outer surface of the cell membrane. In this context, this article comprehensively explores the mechanism of action of various antibiotic classes and emphasizes the promising compounds currently in late clinical development. Common mechanisms of action of antimicrobials basic sites of antibiotic activity adapted from murray, rosenthal, pfaller. medical microbiology, 5th edition, elsevier mosby 2005.
Comments are closed.